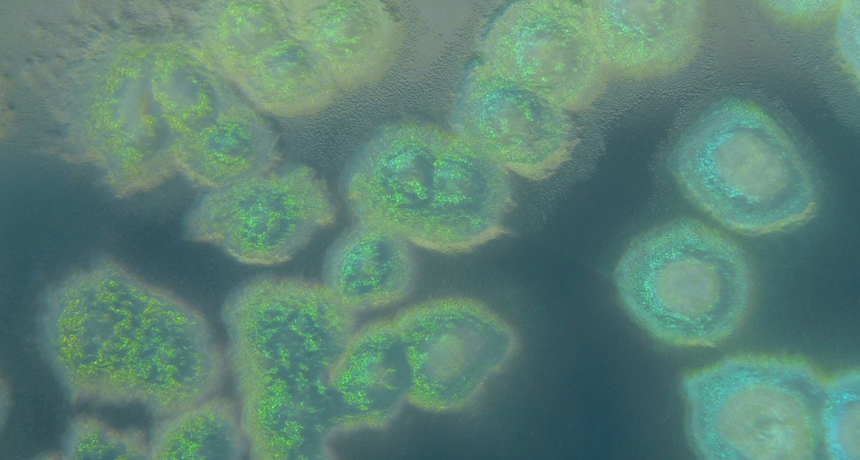

Bacteria linked to stress-induced heart attacks
The bacterium Pseudomonas aeruginosa can release potentially dangerous enzymes when exposed to the stress hormone norepinephrine that may start a cascade of events ending in a heart attack, a new study suggests.
HansN./Wikimedia Commons (CC BY-SA 3.0)







